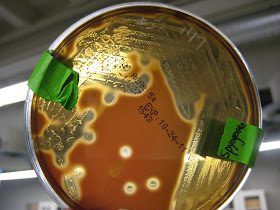

I am happy to say that the semester is just about over, and other then loose ends of finals (arg!) we are just about done. I am also amazed that this site got over 4,500 views in one semester! Wow that's Awesome! It's been a great semester... finish strong and I'll see you around. : )
***** Note that I will NOT be updating this site so the information provided is from Gard Microbiology Fall 2011 semester. If you have questions email me/make a comment, but other then that good luck with finals.
Photographs of the slides seen during a Microbiology lab at Diablo Valley College, Fall 2011, with Professor Karen Gard
Monday, December 5, 2011
Sunday, November 27, 2011
Second Lab Midterm Key Species
As a last and final post, I thought I would summarize all the weird species names for our second Lab Exam. At the end, pathogens for our last lab are grouped according to the Etiologic Agent, because I was having trouble keeping track of which one was what. Hope this helps, happy studying : )
E.coli= MR-> mixed acid pathway for carb fermentation
Enterobacter aerogenes=VP-> 2,3 butanediol for car fermentation
Cauliflower mosaic virus= 35S promotor for GM foods
Agobacterium tumefaciens= NOS terminator for GM foods
Micrococcus luteus=stimulated epidemic -grows yellow
Staphylococcus aureus= common pathogen with beta hemolytic pattern- did passive agglutination test on
Streptococcus pyogens=common pathogen with beta hemolytic patter= did modified direct ELISA
Streptococcus mutans= forms dental caries by making biofilm on tooth surface aka= Initiation of dental caries
Lactobacillus acidophilus= colonizes biofilm and produces lactic acid aka= Progression of dental caries
Pathogens (10 total)
Bacteria=
1. Bacillus antrhracis= Anthrax= gram + rod
2. Nesseria gonorrhoeae= Gonorrhea= gram - diplococcus
Protozoa
1. Giardia lamblia= Giardiasis
2. Plasmodium falciparum= Malaria
3. Trypanosoma brucei gambiense= African Trypansomiasis (African Sleeping Sickness)
Helminths
1. Cestode (tapeworm)= Taenia solium= Cysticercosis
2. Nematode (roundworm)= Ascaris lumbricoidies= Ascariasis
3. Trematode (flatworm)= Schistosoma mansori = Schistosomiasis
Virus
1. Epstein Barr Virus= Infectious mononucleosis= "mono"
Yeast
1. Candida albicans= Candidiasis/ Vaginal yeast infection/ Thrush
E.coli= MR-> mixed acid pathway for carb fermentation
Enterobacter aerogenes=VP-> 2,3 butanediol for car fermentation
Cauliflower mosaic virus= 35S promotor for GM foods
Agobacterium tumefaciens= NOS terminator for GM foods
Micrococcus luteus=stimulated epidemic -grows yellow
Staphylococcus aureus= common pathogen with beta hemolytic pattern- did passive agglutination test on
Streptococcus pyogens=common pathogen with beta hemolytic patter= did modified direct ELISA
Streptococcus mutans= forms dental caries by making biofilm on tooth surface aka= Initiation of dental caries
Lactobacillus acidophilus= colonizes biofilm and produces lactic acid aka= Progression of dental caries
Pathogens (10 total)
Bacteria=
1. Bacillus antrhracis= Anthrax= gram + rod
2. Nesseria gonorrhoeae= Gonorrhea= gram - diplococcus
Protozoa
1. Giardia lamblia= Giardiasis
2. Plasmodium falciparum= Malaria
3. Trypanosoma brucei gambiense= African Trypansomiasis (African Sleeping Sickness)
Helminths
1. Cestode (tapeworm)= Taenia solium= Cysticercosis
2. Nematode (roundworm)= Ascaris lumbricoidies= Ascariasis
3. Trematode (flatworm)= Schistosoma mansori = Schistosomiasis
Virus
1. Epstein Barr Virus= Infectious mononucleosis= "mono"
Yeast
1. Candida albicans= Candidiasis/ Vaginal yeast infection/ Thrush
Tuesday, November 22, 2011
Lab 38 Pathogens
-Infectious diseases caused by pathogenic organisms and agents are the leading cause of death worldwide and a major cause of death in US
-Interestingly, greater than 60% of the world’s population is infected with parasitic helminths (nematodes (roundworms), cestodes (tapeworms), and trematodes (flukes)) although many show mild or no symptoms
-In this lab, we identified microscopic pathogens and described the main features of the disease caused by each pathogen including: etiologic agent, symptoms (sx), and mode(s) of transmission.
1. Pathogen =Neisseria gonorrhoeae (smear of pus discharge)
-Disease= Gonorrhea
-Etiologic agent= Gram-diplococcus (bacterium)
- Sx= May be subclinical, pus discharge from ureathra, painful urination, scarring may lead to sterility and ectopic pregnancy, possible PID (pelvic inflammatory disease) in females
-Modes of Transmission:
1. Sexually transmitted Disease (STD)
2. Mother to baby= ophthalmia neonatorum = baby gets eye infection of gonorrhea as it passes through birth canal
Gonorrhea-notice the little dots-those are Neisseria gonorrhoeae the red puffy cells are neutrophils
2. Pathogen= Taenia solium (muscle tissue- find cysticerus ie. cyst)
- Disease= Cysticercosis
- Etiologic agent=tape worm (cestode)
-Sx= worms stay in muscle and dont cause symptoms, but can create cysts (lesions) at site of infection which include muscle, brain, eye, and heart
-Mode of transmission= Fecal/oral
3. Pathogen= Trypanosoma brucei gambiense (in blood smear)
Disease= African trypanosomiasis/African sleeping sicknes
Etiologic agent=protozoa
Sx= 2 phases
1. Haemolymphatic phase= enlarged lymph nodes, anemia, endocrine, cardiac, and kidney dysfunctions
2. Neurological phase= invades NS= disrupted sleep cycle, daytime slumber and night insomnia, coma
Mode of Transmission= fly=Tsetse fly
4. Pathogen= Ascaris lumbricoides (fecal smear- find mammillated eggs)
-Disease= Ascariasis
-Etiologic agent= Nematode= roundworm
- Sx= usually no sx, but can include bloody sputum, shortness of breath, vomiting worms, worms exiting nose/mouth, worms in stool, skin rash
-Mode of transmission=Fecal/oral
5. Pathogen= Epstein-Barr virus (blood smear- find Downey cells)
*note- Downey cells= deranged lymphocytes= misshapen cell and nucleus of lymphocyte
Disease= Infectious mononucleosis (ie. mono)
Etiologic agent= virus
Sx= flu like symptoms, possible jaundice
Modes of transmission= oral transmission through saliva
Zoom out of picture above, this is what slide looks like, its a blood smear
Downey cells were kind of hard to identify
6. Pathogen= Bacillus anthracis(in lung tissue)
-Disease=Anthrax
-Etiologic agent= Gram + rod=bacterium
-Sx= fever, cough, shortness breath, shock
-Mode of transmission- since we are looking at lung tissue, mode of transmission= inhalation= airborne
7. Pathogen= Plasmodium falciparum (blood smear-seen as purple dot or "loop" within RBC)
- Disease= Malaria
-Etiologic agent=protozoa
-Sx= flu like symptoms, anemia, bloody stool, coma, jaundice, muscle pain
-Mode of transmission= mosquitos
8. Schistosoma mansoni (fecal smear- find egg)
Disease= Schistosomiasis
Etiologic agent= trematode= flatworm
Sx= Liver/spleen enlargement, itchy rash on skin, frequent/painful/bloody urination
Modes of transmission= contact with contaminated water (guessing Fecal/oral)
9. Pathogen= Candida albicans (smear of discharge)
-Disease= Candidiasis/ Vaginal yeast infection/thrush
-Etiologic agent= yeast=fungus
- Sx= vulval itching, soreness, irritation, vaginal discharge (thick and white like cottage cheese)
- Modes of transmission - this disease is NOT transmissible (ie. noncommunicable)-bc:
-it is a normal flora of the vagina
- problems occur when normal flora are off balance ex. like after taking antibiotics
10. Pathogen= Giardia lamblia (fecal smear-find trophozoite= what it looks like during stage inside person= looks like a teardrop)
-Disease= Giardiasis
-Etiologic agent= protozoa
- Sx= Gas/bloating, loss of appetite, swollen (distended) abdomen, vomiting
-Mode of transmission= fecal oral
Note* these are the pictures I took in class, and its really hard to find the trophozoite- if you look kinda in the middle there is a round dark greenish dot, and just above that is the trophozoite -like I said, it is really hard to see
Lab 35: Oral Microbiota
Oral microbiota=normal flora found in the oral cavity
-these organisms colonize the teeth, gums, tongue, cheek mucosa, and salivary glands where warm, moist, nutrient-rich and diverse oxygen environments are present
-most common oral bacteria= streptococci, but hundreds of different species are present, including yeasts
-since bacteria are firmly attached in the oral cavity, they resist removal by the abrasive actions of the teeth, tongue and food, and by the flow of saliva
-the main method of removal is sloughing of mucosa, something teeth can’t do, bc of this, the teeth harbor a great abundance of bacteria
-teeth form biofilms= plaque
-inside each gram of plaque- billions of bacteria, esp. in pits and crevices
-plaque resists penetration of saliva, which contains lysozyme and other antimicrobial factors
-plaque build up is important in 2 oral diseases:
1. dental caries (cavities)
2. Periodontal disease
In this lab= we gram stain smears of plaque from a tooth surface and from gingival crevice (where gums meet teeth) to examine diversity of oral microbiota
Note*
your teeth should have less bacteria then your gingival crevice
-How to Identify slides from the mouth, they will contain:
1. Diversity- rods/cocci, gram +/- etc.
2. Cheek cells= large purple epithelial cells from mouth
Here are some examples of Gram Stained Oral microbiota (note presence of cheek cells)
Here are some examples of Gram Stained Oral microbiota (note presence of cheek cells)
Monday, November 21, 2011
Lab 36 Dental Caries
- Dental caries= also called cavities or tooth decay
a. comprise one of the most common infectious diseases of humans worldwide
b. caries start as small erosions in tooth enamel
-if not treated, they can penetrate into the dentin and pulp cavity- causing pain, infection, and even tooth breakage when biting down
c. Bacteria and diet are important in the initiation and progression of dental caries
Initiation=
Initiation=
1. Bacteria=various oral streptococci (bacteria) establish a biofilm on the surface of the tooth
esp. Streptococcus mutans =cariogenic bacteria- forms dental caries
2. Sugar= a diet high in sucrose will encourage adherence of bacteria to the tooth surface
-bacteria use exoenzymes to break down the disaccharide, sucrose, into the monosaccharide subunits= glucose and fructose
-the energy released by this process, in conjunction with the enzyme, dextransucrase, is used to polymerize the glucose into the polysaccharide dextran
-Dextran= polysaccharide of glucose, forms sticky capsules around the bacteria which allow them to adhere to the tooth surface
-the remaining fructose is then fermented into lactic acid
Progression=
1. oral lactobacilli, including Lactobacillus acidophilus, and other bacteria also colonize the biofilm and produce lactic acid as a product of sugar fermentation
plaque= the multispecies biofilm, dextran capsules, and debris
2. the acids produced by plaque bacteria decalcify tooth enamel below pH of 5, creating erosions
-since the tooth surface does not slough cells like mucosa, plaque remains attached
-although the flushing action and antimicrobial chemicals of saliva do help keep plaque in check, plaque is not very permeable to acid neutralization by saliva
- the bacteria, meanwhile, thrive in highly acidic environment
In this lab, we grow oral bacteria from our saliva on popsicle sticks (which acts as tooth surface)
-one stick in sucrose broth= lots of colonies formed
cariogenic bacteria will adhere to the popsicle stick
-the number of S. mutans in saliva has been correlated with potential to form caries
-other stick in xylitol broth = no colonies formed
-xylitol= a sugar alcohol used to sweeten “sugar-free” stuff
-is non-cariogenic bc it cannot be converted to dextran
Thursday, November 17, 2011
HIV/AIDS WORKSHEET
HIV/AIDS WORKSHEET
1. Approximately what percentage of women were estimated to be living with HIV in 2009 globally? 48%
2. Which region of the world has the most people living with HIV?
-Sub-Saharan Africa
3. Which region of the world had the highest death rate from AIDS during 2009?
-Sub-Saharan Africa
4. What is the trend in cumulative number of AIDS cases in California as of June 30, 2011? It is increasing
5. What is the trend in named HIV cases in California as of June 30 2011?
It is increasing
6. Which 3 California counties have the highest cumulative number of HIV cases as of June 30,2011? Where in the top ten is Contra Costa County? CCC=#10
#1- LA
#2= San Francisco
#3= San Diego
7. Which 3 California counties have the highest cumulative number of AIDS cases as of June 30, 2011? Where in the top ten is Contra Costa County? CCC=#10
#1- LA
#2= San Francisco
#3= San Diego
Ie. same answer as #6
8. What is the most common risk factor for HIV and Aids (taken together) in CCC:
a. In males= males having sex with males (MSM)
b. in females= Heterosexual sex
9. Which Contra Costa cities have the highest and lowest number of people living with AIDS and HIV in
a. West county?
high= Richmond
low= Kensington
b. Central county?
high= Concord
low= Moraga
c. East county?
high= Pittsburg
low= Brentwood
Lab 31: Streptococcus pyogenes Rapid Test
Lab 31: Streptococcus pyogenes Rapid Test
1. Rapid tests= immunological assays that use Ag-Ab reactions to identify a specific organism or agent
-tests give results within minutes and can be run in hospital labs/dr.s offices
In this lab, we see a demonstration of Streptococcus pyogenes modified direct ELISA test (“sandwich assay”= Ab-Ag-Ab)
2. Modified DIrect Elisa Test
-uses a paper stip that has an area embedded with anti-Strep antibodies to detect S. pyogenes in a sample
- samples are taken from Beta hemolytic colonies cultured from throat swab grown on sheep’s blood agar plates
How Test Works-
1. Sample with possible S. pyogenes is added to test tube which contains anti-Strep antibodies conjugated with a blue dye
-if S. pyogenes is present they bind to anti-Strep antibodies
2. A paper strip is then placed into the tube and Ag-Ab complexes wick up strip
3. Area 1= contains anti-Strep antibodies attached to the strip
-as the fluid wicks up the strip, if Strep Ag---anti-Strep antibody complexes are in it, the Strep Ag will bind to the anti-Strep antibodies attached to the strip
-ie. it forms an Ab-Ag-Ab with blue dye
-the blue dye causes a blue line to form in this area
+reaction= blue strip and pink line
- reaction= just pink line
4. Area 2=Pink line= as the fluid continues to wick up the strip, a pink line confirms that the test is functioning properly
ie. the fluid wicked past area 1 with attached antibodies
-so if no lines appear or just blue line-something is wrong with test
Positive Negative
Lab 30: Staphylococcus aureus Rapid Test
Lab 30: Staphylococcus aureus Rapid Test
1. Rapid Tests= immunological assays that use Ag-Ab rxns to identify a specific organism or agent
-give results within minutes and can be run in hospitals labs or dr. offices
-In this lab, we do Passive Agglutination Test for Staphylococcus aureus
Passive Agglutination Test= uses latex beads coated with anti-Staph antibodies to detect S. aureus
-test kit comes with positive and negative controls
-test samples come from beta hemolytic colonies cultured from throat swabs grown on sheep’s blood agar plates
+= if S.aureus antigen is present and binds to Abs= agglutination = clumping
-= no clumping
-Indications of Positive Test
a. A Positive test combined with appropriate signs/symptoms can confirm dx of S.aureus infection
S. aureus= Gram + non motile coccus
-responsible for wide array of diseases including:
a. skin infections= most common
-including: pimples, impetigo, boils, carbuncles, and cellulitis
b. surgical and would infections are common and can spread to internal organs causing other disease like pneumonia or septicemia
c. Staphylococcal food poisoning and toxic shock syndrome from toxins produced from certain strains of Staph
b. Can indicate that person is a healthy carrier= healthy, asymptomatic carrier of S. aureus in their noses/throats or skin, but NO symptoms of disease
-25-50% of population =health carriers of S. aureus
-healthy carriers can still spread Staph to others
-even resistant strains of Staph like MRSA (methicillin-resistant S. aureus) can be found in healthy carriers
- important for healthcare workers who are healthy carriers but are alsoaround immunocompromised patients- could be very harmful if spread to them
Wells 4,5, 10= positive =clumping
Well 9= negative= no clumping
Lab 34: Throat Culture
Lab 34: Throat Culture
1. Pharynx=Throat= warm, moist environment that houses a mixed normal flora with organisms from both the upper respiratory and digestive tracts
-besides normal flora, the pharynx can also harbor potentially pathogenic bacteria
-these pathogens are kept in check by normal flora, but they can cause disease if they breach this barrier or are transmitted to vulnerable individuals
-In this lab, we take throat swabs from nasopharynx, which is the respiratory part of the pharynx (in the far back region of throat, behind uvula)
2. Growth medium= sheep’s blood agar plates-contains 5% sheep’s blood, and is a differential medium agar which helps to categorize bacteria by hemolysis patterns -=how bacteria destroy RBCs (hemo- RBC; -lysis= burst)
ie. differential medium agar for hemolysis patterns
3. Hemolysins=toxins produced by colonies that cause either partial or dotal destruction of surrounding RBCs
4. We see Three Hemolysis Patterns:
1. Alpha (α) Hemolysis= partial clearing and greenish pigmentation around colonies
a. Alpha hemolytic bacteria:
1. are normal flora
2. MOST COMMON bacteria in throat
2. Beta (β) Hemolysis= complete lysis of RBC around colonies resulting in a clearing
a. Beta hemolytic bacteria:
1. usually pathogens
ex. Streptococcus pyogenes
Staphylococcus aureus
3. Gamma (ɣ) hemolysis= no clearing or surrounding ring, just dark colony with sheep’s blood agar surrounding it
a. Gamma hemolytic bacteria= normal fora
Colonies on upper right are Alpha Hemolytic
Mix of Alpha, Beta, and Gamma
Mix of Alpha, Beta, and Gamma
Pure Beta hemolytic bacteria
Pure Beta Hemolytic bacteria- notice the huge clearing
Wednesday, November 16, 2011
Lab 29: Quantitative ELISA
ELISA (Enzyme-linked immunosorbent assay)= an immunodiagnostic test used to measure specific antigens or antibodies in an unknown sample
-test is often used to detect the presence or even specific levels of substances such as drugs, hormones, foods, and pathogens
-test is relatively inexpensive, simple, and easily interpreted
-each test is run in a small plastic well on a microtiter plate= plate with multiple wells for test
-test works bc of antigen-antibody specificity
-Testing for Unknown Antigen= the unknown antigen will adhere to its specific antibody in the test well
-Testing for Unknown Antibodies= the unknown antibody will adhere to its specific antigen in the test well
*in both types of tests an antibody- enzyme conjugate is added
Antibody-enzyme conjugate= another antibody that is linked to an enzyme
-this enzyme catalyzes a color change rxn in the presence of its substrate, a chromagen
-chromogen= chemical that can undergo a color change rxn
-2 Types of Info Obtained from ELISA
1. Qualitative ELISA test= a color change is enough to confirm a positive result
Ex. Pregnancy test, or peanut contamination in food- these are yes/no results
2. Quantitative ELISA test= the level of the substance is also assessed
-to do this, the intensity of the color change is read with a spectrophotometer=gives an absorbance reading which is proportional to the amount of antigen or antibody
Ie. High absorbance= high amount of Ag or Ab
-the results are then compared to absorbance readings from known amounts of Ag or Ab
- we then plot these known values on a graph called a standard curve to be able to determine the level of unknown from the graph
-2 Types of ELISA tests: Direct and Indirect
1. Direct ELISA= “sandwich assay”= tests for an unknown Antigen
a. well is coated with known Antibody for the specific antigen to be tested
b. sample is added with unknown antigen, and if present antigen will bind to Antibody
c. Wash= any unbound material is then washed away
d. Antibody-enzyme conjugate is added
e. Wash- unbound material is again washed away
f. Chromogen added
color change= positive test= yes Ag
no color change= negative= no Ag
-sandwich assay- bc it creates a symmetrical grouping of Ab-Ag-Ab
Ex. Direct ELISA= pregnancy test, influenza test
2. Indirect ELISA= tests for an unknown Antibody
a. Well coated with known Antigen for the specific antibody to be tested
b. Sample is added – if antibody present will bind to Ag
c. Wash- unbound material is washed away
d. Antibody-enzyme conjugate added
-this is actually an anti-antibody, bc it adheres to the specific class of Ab that we are testing for
e. Wash- unbound material washed away
f. Chromogen added
positive= color change
negative= no color change
ex. Indirect ELISA= HIV antibodies-> bc HIV antigens hide in infected cells and can be harder to find in serum samples
In this lab- we do indirect ELISA test for salivary IgA antibodies
IgA= predominant secretory Ab (ie. Found in secretions-saliva, tears)
- IgA can inhibit bacteria that contribute to dental caries= cavities
- Prediction= increased IgAs= decreased cavities bc it inhibits bacteria that cause cavities
*Note- that for our indirect ELISA- the test wells have anti-human IgA adhered to them – this is our Ag
-this is known as a capture antibody- acts like an Ag for Ab- we got by injecting into goats and collecting the Abs made by goat
Brief Outline of our Steps- we do a Indirect Quantitative ELISA for Salivary IgA
- Add saliva sample which contains IgA to test wells with anti-human IgA adhered to them
- Wash
- Add anti-human IgA Ab conjugated to the enzyme horseradish peroxidase (HRP)
- Wash
- Add TMB chromogen= HRP enzyme substrate-
ie if HRP is bound and present TMB chromogen will cause it to change color
Color change should occur- then we place microtiter plate into the ELISA plate reader= spectrophotometer=determines the absorbance readings
Determine amount of salivary IgA- we do this by creating a standard curve of absorbance readings of known concentrations of human IgA (ie. We graph standards of known concentrations and their known absorbance’s)
For Graph= makes it a quantitative
X=concentration of IgA standards
Y= absorbance (from spectrophotometer)